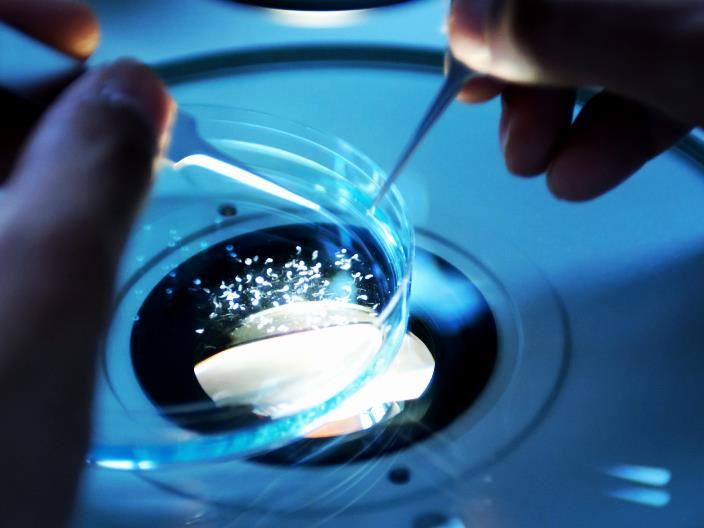

세계 경제 포럼은 인도의 4차 산업혁명 센터를 기반으로 하는 첫 암치료(FIRST Cancer Care) 이니셔티브는 기술 발전이 암 치료에 혁명을 일으킬 수 있는 방법을 탐구하고 암으로 영향을 받는 인구를 위해 평등하고 지속 가능한 의료를 보장하기 위한 조치를 추진한다. 이 이니셔티브는 포럼의 이해 관계자 중심 접근 방식을 반영하며 결과가 사회에 광범위하게 도움이 될 것이라는 기대에 기반을 두고 있다.

팬데믹이 완화됨에 따라 전 세계 커뮤니티는 암 진단, 치료 및 치료에 대한 품질과 공평한 접근을 보장하는 우선 순위를 다시 지정하려는 움직임이 대두 되고 있다.
COVID-19는 암 환자에게 치명적인 영향을 미쳤으며 COVID-19가 의료 시스템에 가한 제약으로 인해 진단 및 치료가 지연되었다. 2019년에 전 세계적으로 약 2,360만 건의 새로운 암 사례와 1,000만 건의 암 사망이 발생했으며, 이는 2010년에 비해 신규 사례가 26.3%, 사망자가 20.9% 증가한 수치라고 세계보건기구(World Health Organization,WHO)가 발표했다.
지속 가능한 변화를 위한 4차 산업 혁명(FIRST) 암 치료 보고서는 임상의, 학계, IT 및 제약 회사, 공중 보건 전문가 및 시민 사회를 포함한 30명 이상의 이해 관계자가 45개 이상의 회의에서 브레인스토밍을 통해 논의한 결과보고서가 나왔다.

◇암이 두렵지 않은 세상
지멘스 헬시니어스 CEO 베른트 몬탁(Bernd Montag) 박사는 암이라는 '숨겨진 대유행'이 익숙해져야 한다고 생각하지만 받아들여서는 안됩니다. “COVID-19와 마찬가지로 우리는 힘을 합쳐 이 계속 증가하는 전 세계 건강 부담을 해결할 수 있습니다. 전염병은 우리에게 세 가지 교훈을 가르쳐 주었다.”고 말했다.
몬탁박사는 “과학이 중요하다”고 말했다. 특히 의료영상 분석연구실(The Laboratory of Medical Imaging and Computation, LMIC)에서 전 세계적으로 암 부담이 증가하고 있다. 암과 싸우려면 가능한 한 조기에 정확하게 발견하고 치료해야 합니다. 저선량 CT와 같은 혁신이 가능한 국가 폐암 검진 프로그램은 사망률을 줄이는 데 도움이 될 수 있다고 말했다.”
“기술이 중요합니다” 의료 전문가의 공급 감소와 함께 의학적 증거가 급격히 증가함에 따라 디지털화는 환자와의 격차를 해소할 수 있습니다. 우리는 예를 들어 COVID-19 환자를 위한 원격 진료와 의사 결정을 지원하는 AI 기반 조수와 함께 좋은 경험을 했습니다. 이러한 경험은 암 환자의 치료로 이전될 수 있습니다.
“의료는 팀 접근 방식입니다.” 방사선과 전문의, 종양 전문의, 외과의, 간호사, 의료 기술 및 제약 산업, 그리고 암 환자 치료에 관련된 많은 다른 사람들이 있습니다. 우리는 함께 암을 관리 가능한 만성 질환으로 바꾸어 암에 대한 두려움을 없애기 위해 노력하고 있습니다.
◇정밀종양학 접근성
제네론 헬스(Genetron Health) 공동 창립자 겸 CEO 시천 왕(Sizhen Wang) 박사는 정밀 종양학은 암을 물리칠 수 있는 최고의 새로운 무기입니다. 정밀 의학의 기반이자 관문인 유전자 염기서열 분석은 유전적 변이를 감지하여 인체의 변화를 찾아내고 진단과 치료를 안내할 수 있다고 말했다.
의사와 환자 모두 이 무기가 필요합니다. 그들은 단순하고 표준적인 운영 절차, 더 짧은 회전 시간, 더 적은 수의 테스트 샘플, 더 낮은 치료 비용을 갖춘 더 안정적이고 신뢰할 수 있는 의료 솔루션이 필요합니다. 정밀 종양학의 선구자로서 우리는 기술 혁신이 이러한 발전하는 임상 수요를 충족할 수 있고 미래에 훨씬 더 정확하고 접근 가능한 의료 서비스를 통해 환자에게 더 많은 혜택을 가져다 줄 것이라고 믿습니다.
혁신적인 '차세대 염기서열 분석' NGS(Next-Generation Sequencing) 방법은 암 관리의 전체 주기를 최적화하는 데 도움이 됩니다. 이러한 고급 시퀀싱 기술은 조기 검진에 적용하여 암 환자의 수명을 연장하고 완치율을 향상시킬 뿐만 아니라, 의사가 1차 치료 후 암 환자의 후속 개발을 정확하게 재배치할 수 있습니다.
NGS 기반 플랫폼은 또한 암 약물의 동반 진단(CDx) 테스트의 개발과 새로운 암 약물에 대한 연구를 효과적으로 지원합니다.
게놈에서 클리닉에 이르기까지 기술 혁신을 통해 우리와 같은 생명 공학 회사는 정밀 종양학 기술의 R&D 투자; 다양한 의료 제품 및 서비스 제공, 보다 전문적이고 공적인 교육 프로그램을 시작합니다.
◇4차산업 기술 도입
라일라바티(Lilavati)병원 연구센터 외과종양학과 회장인 팔레푸 자간나트사(Palepu Jagannath) 박사는 개발도상국의 약 4분의 3이 표준 암 치료에 대한 접근이 부적절합니다. 미국 임상종양학회(American Society of Clinical Oncology)에 따르면 저소득 및 중간 소득 경제(LMIC)에서 암에 걸린 사람들의 약 66%(고소득 국가에서는 50% 미만)가 암으로 사망한다고 밝혔다.
인도 세계경제포럼의 4차 산업혁명 센터는 AI, 머신러닝, 사물인터넷과 같은 신기술을 활용하여 암 치료의 질을 변화시키는 것을 목표로 First Cancer Care(FCC) 프로젝트를 시작했다. 전문가 그룹은 암 치료에 대한 접근성을 개선하기 위한 중요 프로세스를 확인했다.
▲원격 의료, 즉 전문가 상담 및 임상 치료를 개선하기 위한 가상 종양 게시판을 운영한다. ▲구강암, 유방암 및 자궁경부암의 조기 진단으로 이어지는 의료 종사자에 의한 AI 기반 위험 프로파일링 및 일반적인 암의 기회주의적 스크리닝 분석. ▲임상 유방 검사 및 유방 조영술을 보완하기 위해 커뮤니티에서 유방암 검진을 위한 새로운 도구입니다. ▲비종양 전문의와 간호사를 1차 진료 제공자로서 교육하여 분산된 암 진료를 제공한다. ▲암 진단을 개선하기 위한 생검 및 원격 병리학의 원격 처리 ▲인공 지능 기반 흉부 엑스레이 영상 분석으로 폐암 식별 ▲디지털 건강 기록을 체크한다. 스마트폰과 클라우드 기반 데이터 캡처를 사용하여 환자 여정을 매핑하여 연속 치료를 제공한다.
전반적으로 특정 격차에 대한 4IR 기술의 채택은 암 치료를 개선할 수 있으며시범 프로젝트는 주 전체, 국가 및 전 세계적으로 확장된다.
◇가장 큰 지렛대 하나는 '조기 발견'
시리아크 로딩(Cyriac Roeding) 얼리(Earli) 설립자는 100년 후인 2122에는 지난 2022년에 우리 몸 어딘가에서 암이 자라고 있는지 여부를 알지 못했다는 것을 상상하기 어려울 것입니다. 우리 몸은 매일 밤 잠자는 동안 문제가 있는지 자동으로 검사되지 않았습니다.
"분자 나노입자 스파이"는 악성 종양에 직면했을 때 신호를 보내기 위해 끊임없이 우리 몸을 돌아다니며 모니터링 했습니다. 그리고 그 환자들은 폐에서 병변이 발견된 후 치료 없이 집으로 보내지기까지 했습니다. 병변이 악성인지 양성인지 아무도 알 수 없었기 때문입니다.
세계는 면역 요법에서 유전자 요법에 이르기까지 지난 수십 년 동안 암 치료 옵션에서 큰 진전을 이루었습니다. 그러나 생명을 구하는 가장 큰 단일 수단은 조기 암 발견에 있습니다. 상위 5개 암의 5년 생존율은 암의 유형에 따라 1기 대 4기에서 4~13배 더 높습니다.
조기에 선별하고 진단하는 것을 더 잘해야 합니다. 다행히 세 가지 급진적인 혁신이 나타나고 있습니다. 액체 생검은 혈액 샘플에서 암 신호를 찾습니다. AI는 최고의 영상 전문가가 없는 곳에서 신체 스캔을 분석합니다. 합성 생검은 전체 감지 개념을 뒤집습니다. 암을 찾는 대신 합성 생물학을 사용하여 암을 찾아내고 결국 스스로 목숨을 끊도록 강요받고 있습니다.
저는 2122년에 우리가 2022년을 되돌아보고 "그때가 중요한 조기 탐지 기술이 실제로 등장한 때"라고 말할 것이라고 낙관합니다.
◇더 많은 암 치료법이 지평선에 있습니다
칭화대학교 약학부 학장 겸 바이엘 석좌교수 셍딩(Sheng Ding) 박사는 앞으로 10년 동안 많은 암이 완치되거나 잘 관리될 수 있다는 희망이 그 어느 때보다 커졌습니다.
암 이종성을 특성화하기 위한 시퀀싱에 의한 단일 세포 프로파일링, 암 캐주얼 유전자를 식별 및 조작하기 위한 유전자 혁신기술CRISPR(Clustered regularly interspaced short palindromic repeats)에 의한 정밀 게놈 편집, 계속 증가하는 규모의 암 게놈과 같은 새로운 기술 개발에 의해 구동됩니다.
이러한 노력은 암을 조기에 더 잘 진단하고, 새로운 암 치료제를 개발하고, 궁극적으로 암을 예방하기 위한 새로운 표적, 메커니즘 및 접근 방식을 밝혀내고 있습니다.
예를 들어, 우리의 면역 체계를 활용하고 강화함으로써 기존의 소분자 또는 항체 약물 및 또는 다중 조작된 세포를 사용한 면역 요법이 암에 대한 치료 치료법을 제공하기 시작했으며 많은 차세대 면역 요법이 새로운 판독 및 결실을 맺게 되었습니다. AI는 신약 개발 패러다임에 영향을 미치기 시작한 또 다른 분야입니다.
가까운 장래에 생의학 연구는 더 많은 암 치료법을 제공할 것이며, 연구자들은 암의 가장 큰 위험 요인 중 하나인 노화 방지를 포함하여 새로운 영역을 계속 탐색할 것입니다.

◇조기치료는 사망 감소
아스트라제너카(AstraZeneca) 종양학사업부 수석부사장인 데이비드 프레드릭슨(David Fredrickson) 은 과학은 암 치료에서 우리가 더 일찍 행동할수록 환자에게 더 나은 결과를 가져다준다는 것을 입증했다.
팬데믹 이전에 우리는 주로 선별 및 조기 진단의 증가와 개인 맞춤형 의학을 포함한 치료의 발전으로 인해 전 세계적으로 암 관련 사망이 지속적으로 감소하는 것을 보았습니다.
팬데믹은 이러한 추세를 역전시킬 위협이 있습니다. 유럽 ??암 기구(European Cancer Organization)는 COVID-19로 인해 유럽에서 100만 건의 진단 누락이 발생할 것으로 예측합니다.
그리고 미국에서 미국 암 협회 암 행동 네트워크(American Cancer Society Cancer Action Network)는 적극적으로 암 치료를 받고 있는 사람들의 4분의 3 이상이 팬데믹 기간 동안 치료의 일부 측면을 연기해야 ??한다고 보고했습니다.
그러나 팬데믹에 대응하여 전 세계 암 커뮤니티의 획기적인 혁신과 협력에 희망이 있습니다. 한 세대의 가장 큰 건강 위기에서 다시 등장한 지금, 암 위기를 피하기 위해 행동해야 할 때입니다.
이를 위해 우리는 우리가 구축한 파트너십을 유지 및 확장하고 의료 시스템의 회복력과 지속 가능성을 우선시하며 지역 차원에서 검사에 대한 접근성을 확대하기 위해 노력해야 합니다.

